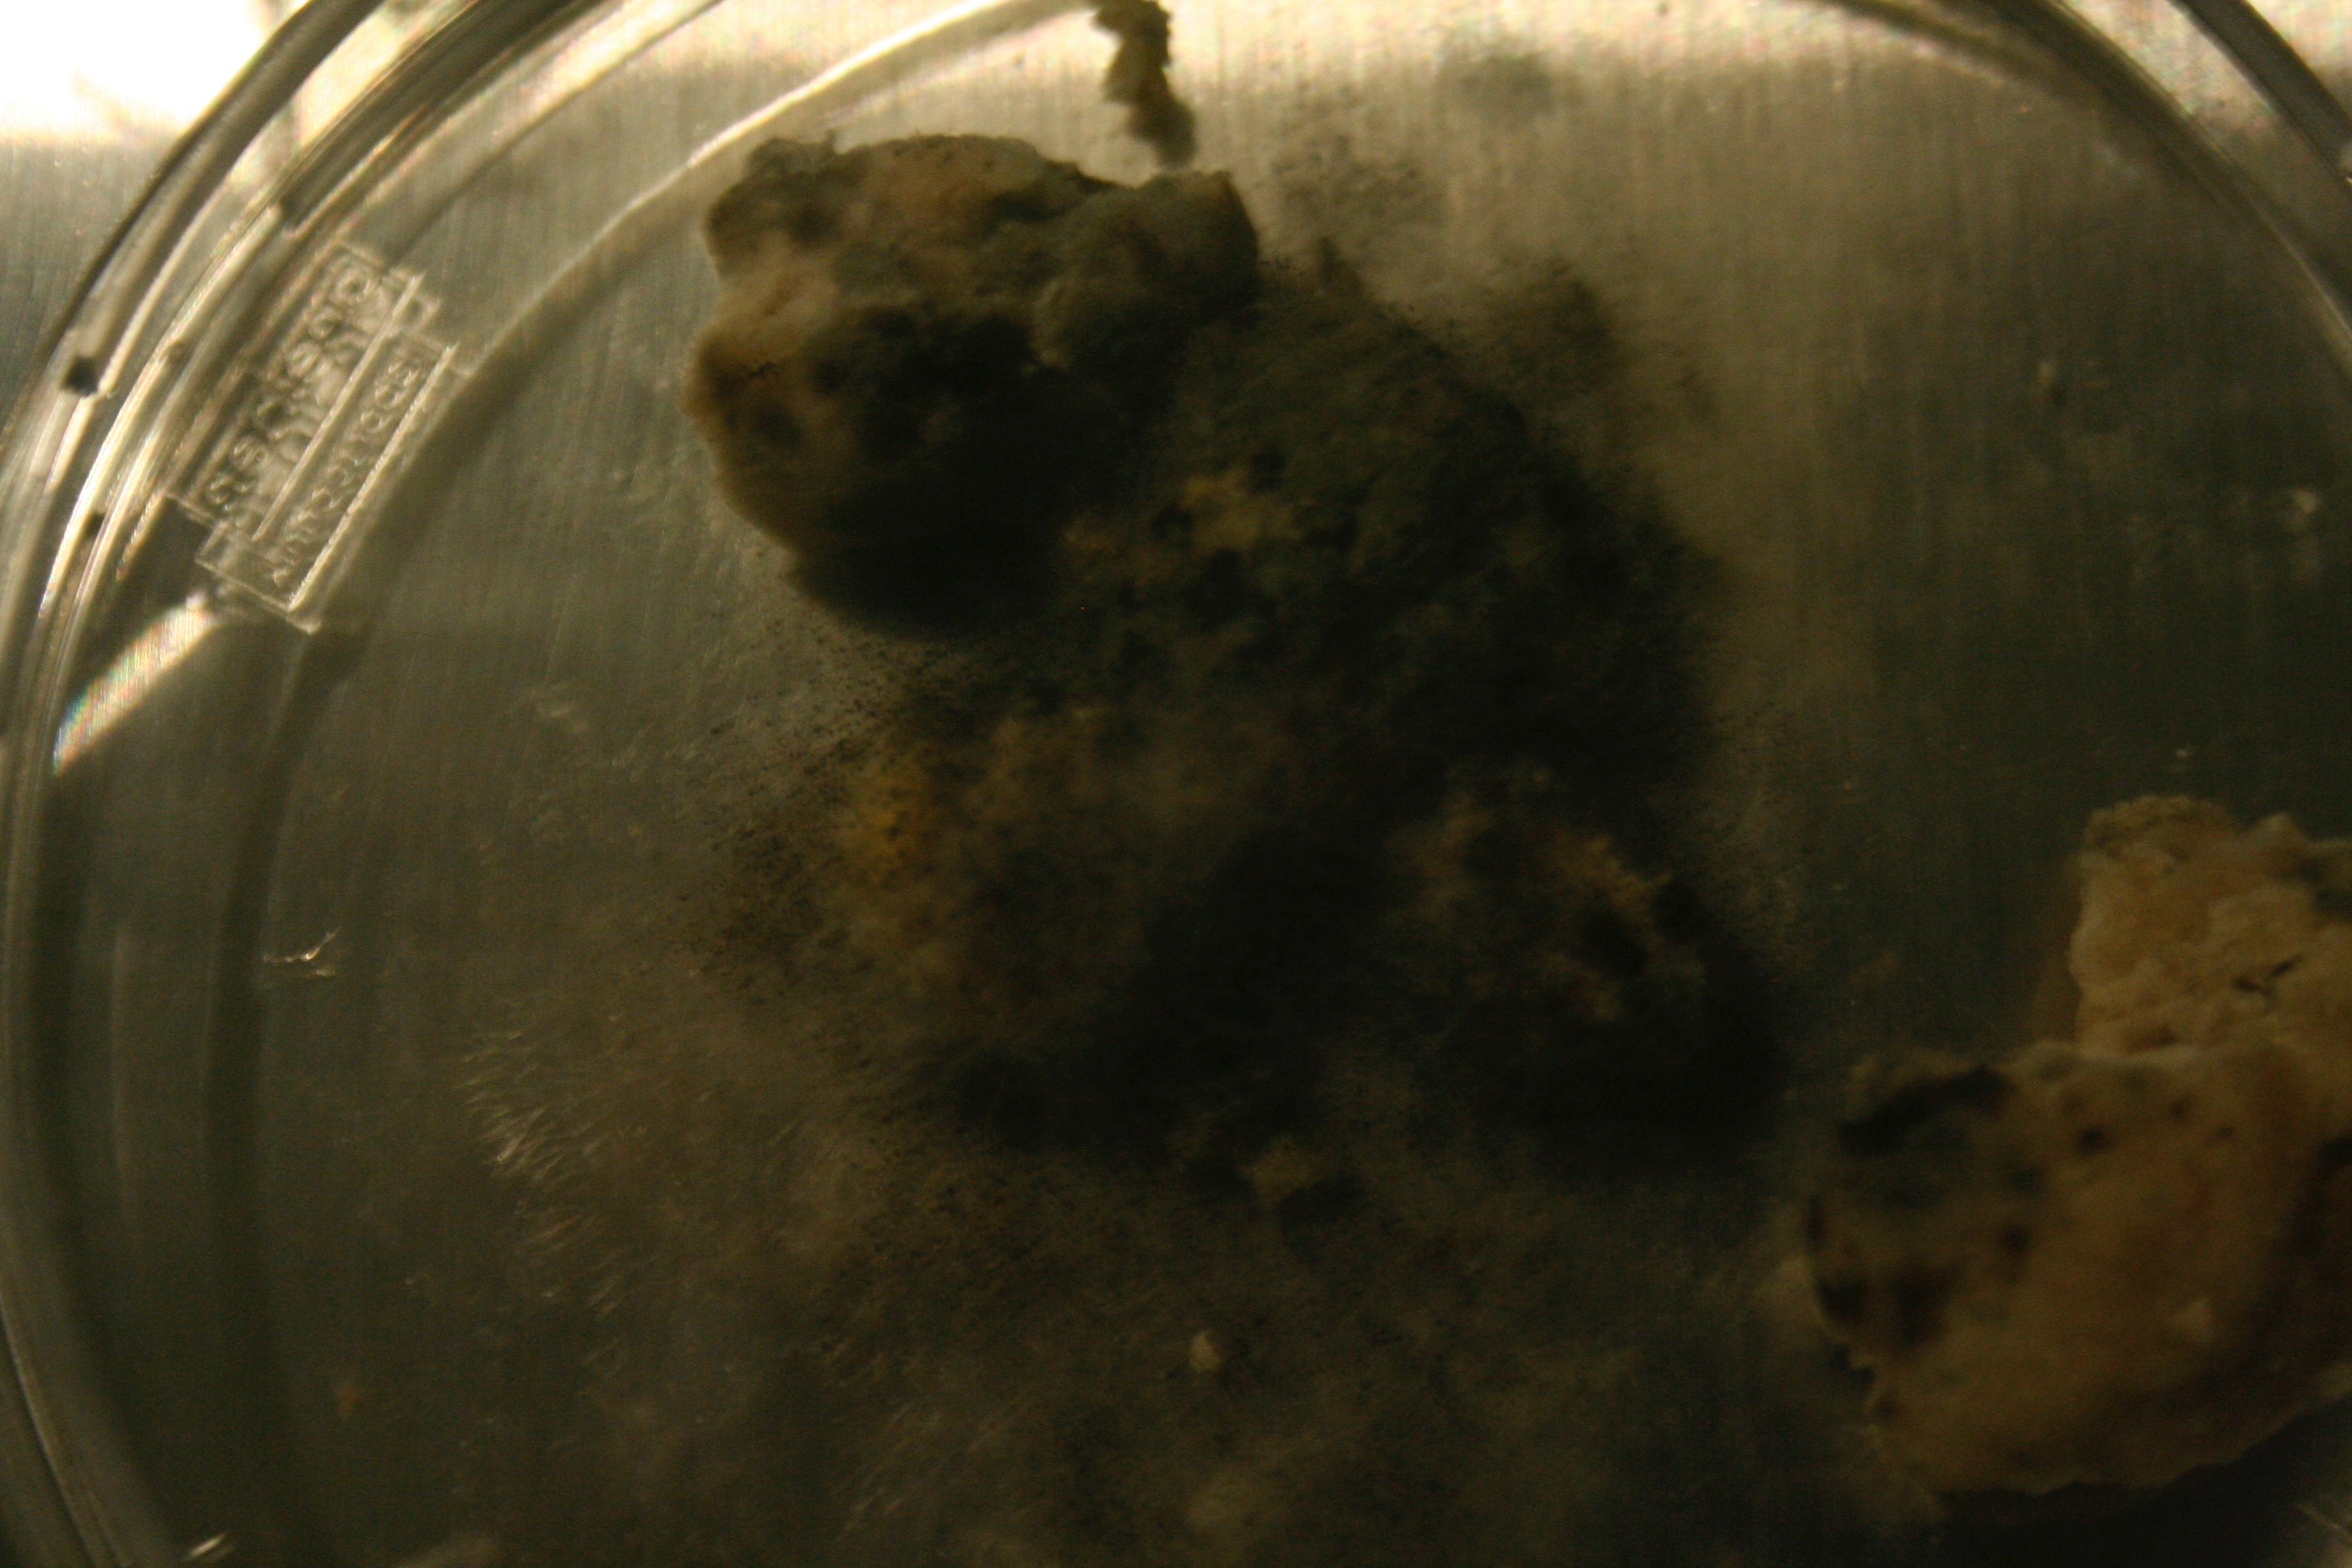

“Los hongos nacen en silencio; algunos nacen en silencio; otros con un breve alarido, un leve trueno… Cada uno trae -y eso es lo terrible- la inicial del muerto de donde procede”
Marosa Di Giorgio
Algunos hongos nacen en silencio, otros con un breve alarido es una investigación que roba el nombre de un escrito de la poetisa uruguaya Marosa Di Giorgio. Una investigación desde el terreno artístico. Una investigación que cultiva y aísla un hongo de nombre aspergillus, -un hongo que germina en pan, verdura y fruta en proceso de descomposición- que será utilizado para infectar discos de vinilo en malas condiciones, buscando su temporal restauración.